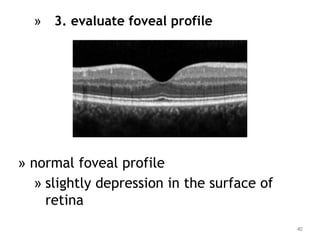
» 3. evaluate foveal profile
» normal foveal profile
» slightly depression in the surface of
retina
40
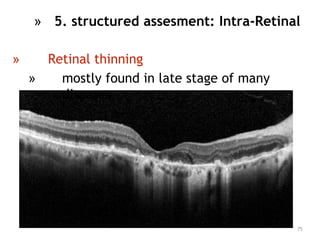
75
» 5. structured assesment: Intra-Retinal
» Retinal thinning
» mostly found in late stage of many
diseases

This document provides guidance on interpreting optical coherence tomography (OCT) scans of the macula in common retinal diseases. It discusses how to acquire high-quality OCT images and systematically evaluate the scans. Key steps in image acquisition include proper scan centration and verification of data quality. When evaluating scans, the document outlines examining scan quality, overall retinal profile, foveal contour, retinal layers, and identifying any abnormalities. Specific pathologies are demonstrated, such as macular edema, holes, detachments, and changes at the retinal pigment epithelium. Overall, the document serves as a guide for clinicians to optimize OCT image quality and systematically read scans to accurately diagnose and monitor macular diseases.